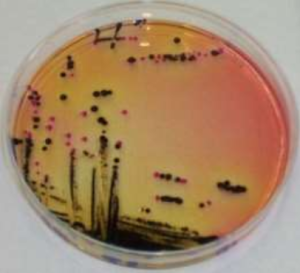

Intended Use
Salmonella Shigella Agar (DM236) is used for the isolation of Salmonella spp. and some strains of Shigella species from pathological specimens and other suspected foodstuffs etc.
Product Summary and Explanation
Salmonellosis continues to be an important public health problem worldwide. Infection with non-typhi Salmonella often causes a mild, self-limiting illness. Typhoid fever, caused by Salmonella typhi, is characterized by fever, headache, diarrhea, abdominal pain, and can result in fatal respiratory, hepatic, and or neurological damage.(1) This infection can result from the consumption of raw, undercooked, or improperly processed foods contaminated with Salmonella spp. Shigellosis, caused by Shigella spp., is an intestinal illness characterized by abdominal pain, fever, and watery diarrhea. When associated with outbreaks, shigellosis is usually transmitted through contaminated food and/or water.
Salmonella Shigella Agar is essentially a modification of the Desoxycholate Citrate Agar described by Leifson.(2) SS Agar is moderately selective and differential media for the isolation of pathogenic enteric bacilli, especially those belonging to the genus Salmonella. It is not recommended for the primary isolation of Shigella. This media has been developed for the selection and differentiation of enteric microorganisms from clinical and non-clinical materials and inhibits the growth of gram-positive species to a varying degree due to the presence of bile salts, brilliant green and sodium citrate.
The high selectivity of Salmonella Shigella Agar allows the use of large inocula directly from faeces, rectal swabs or other materials suspected of containing pathogenic enteric bacilli. On fermentation of lactose by few lactose-fermenting normal intestinal flora, acid is produced which is indicated by change of colour from yellow to red by the pH indicator-neutral red. Thus these organisms grow as red pigmented colonies. Lactose non-fermenting organisms grow as translucent colourless colonies with or without black centres. Growth of Salmonella species is uninhibited and appears as colourless colonies with black centres resulting from H2S production. Shigella species also grow as colourless colonies which do not produce H2S. It is recommended to inoculate plates of less inhibitory media parallel to SS Agar, such as Hektoen Enteric Agar (DM422) or Deoxycholate Citrate Agar (DM577) for easier isolation of Shigella species (8). Salmonella Shigella Agar is recommended for testing clinical specimens and food testing for the presence of Salmonella spp. and some Shigella spp.(1,4,5)
Principles of the Procedure
Beef extract and Peptic digest of animal tissue provide sources of nitrogen, carbon, and vitamins required for organism growth. Differentiation of enteric organisms is achieved by the incorporation of lactose in the medium. Organisms that ferment lactose produce acid which, in the presence of the neutral red indicator, results in the formation of red colonies. Lactose non-fermenters form translucent, colorless colonies. The latter group contains the majority of the intestinal pathogens, including Salmonella and Shigella. Bile Salts, Sodium Citrate and Brilliant Green inhibit Gram-positive bacteria, most coliform bacteria, and inhibit swarming of Proteus spp., while allowing Salmonella spp. to grow. The sodium thiosulfate and ferric citrate enable the detection of hydrogen sulfide production as evidenced by colonies with black centers. Neutral Red is the pH indicator.
Formula / Liter
| Ingredients | : Gms / Litre |
| Beef extract | : 5.00 |
| Peptic digest of animal tissue | : 5.00 |
| Lactose | : 10.00 |
| Bile salts mixture | : 8.50 |
| Sodium citrate | : 10.00 |
| Sodium thiosulphate | : 8.50 |
| Ferric citrate | : 1.00 |
| Brilliant green | : 0.00033 |
| Neutral red | : 0.025 |
| Agar | : 15.00 |
| Final pH: 7.0 ± 0.2 at 25°C | |
| Formula may be adjusted and/or supplemented as required to meet performance specifications | |
Precautions
1. For Laboratory Use only.
2. HARMFUL. Harmful if swallowed, inhaled, or absorbed through the skin. May cause allergic reaction and breathing difficulties. Irritating to eyes, skin, and respiratory system.
Directions
1. Suspend 63.02 grams in 1000 ml distilled/purified water.
2. Boil with frequent agitation to dissolve the medium completely.
3. DO NOT AUTOCLAVE OR OVERHEAT.
4. Overheating may destroy selectivity of the medium. Cool to about 50°C.
5. Mix and pour into sterile Petri plates
Quality Control Specifications
| Dehydrated Appearance | : Light yellow to pink, homogeneous, free flowing powder |
| Prepared Medium | : Reddish-Orange, clear to slightly opalescent gel forms in Petri plates |
| Reaction of 6.3% Solution | : pH 7.0 + 0.2 at 25°C |
| Gel Strength | : Firm, compared to 1.5% Agar Gel. |
Expected Cultural Response: Cultural response on Salmonella Shigella Agar at 35-37°C after 18-24 hours incubation.
| Sr. No. |
Organisms | Results to be achieved | |||
| Inoculum (CFU) |
Growth | Percentage Recovery |
Color of Colonies | ||
| 1. | Escherichia coli ATCC 25922 | 50-100 | Fair | 20-30% | Pink with bile precipitate |
| 2. | Enterobacter aerogenes ATCC 13048 | 50-100 | Fair | 20-30% | Cream pink |
| 3. | Enterococcus faecalis ATCC 29212 | 50-100 | None-poor | <=10% | Colourless |
| 4. | Proteus mirabilis ATCC 25933 | 50-100 | Fair-good | 30-40% | Colourless |
| 5. | Salmonella choleraesuis ATCC 12011 | 50-100 | Good-luxuriant | >=50% | Colourless, may have black cP entre |
| 6. | Salmonella typhi ATCC6539 | 50-100 | Good-luxuriant | >=50% | Colourless with black centre |
| 7. | Salmonella typhimurium ATCC 14028 | 50-100 | Good-luxuriant | >=50% | Colourless with black centre |
| 8. | Salmonella enteritidis ATCC 13076 | 50-100 | Good-luxuriant | >=50% | Colourless with black centre |
| 9. | Shigella flexneri ATCC 12022 | 50-100 | Good | 40-50% | Colourless |
The organisms listed are the minimum that should be used for quality control testing.
Escherichia coli ATCC 25922 + Salmonella enteritidis ATCC 13076
Test Procedure
1. Inoculate the medium heavily with the specimen, spreading a portion of the original inoculum in order to obtain well separated colonies on some part of the plate.
2. For isolation of Salmonella spp. and Shigella spp. from clinical specimens, inoculate fecal samples and rectal swabs onto one quadrant of Salmonella Shigella Agar, streak for isolation.
3. Incubate plates at 35°C, and examine after 24 and 48 hours for colonies resembling Salmonella spp. or Shigella spp.
4. For food specimens consult appropriate references for food testing.
5. In parallel with the SS Agar plate, inoculate a tube of Selenite Broth (DM241) enrichment medium, incubate for 12 hours at 35°C, and sub-culture on to another SS Agar plate.
6. A nonselective medium should also be streaked to increase the chance of recovery when the population of gram-negative organisms is low and to provide an indication of other organisms present in the specimen.
Results
1. Enteric organisms are differentiated by their ability to ferment lactose.
2. Salmonella spp. and Shigella spp. are non-lactose fermenters and form translucent, colorless colonies on Salmonella Shigella Agar. H2S positive Salmonella spp. produce black-center colonies.
3. Some Shigella spp. are inhibited on Salmonella Shigella Agar.
4. E. coli produces pink to red colonies and may have some bile precipitation
Storage
Store the sealed bottle containing the dehydrated medium at 10-30°C. Once opened and recapped, place container in a low humidity environment at the same storage temperature. Protect from moisture and light.
Expiration
Refer to the expiration date stamped on the container. The dehydrated medium should be discarded if not free flowing, or if the appearance has changed from the original color. Expiry applies to medium in its intact container when stored as directed.
Limitations of the Procedure
1. Salmonella Shigella Agar is highly selective and not recommended as the primary isolation of Shigella.(1,2,6) Some Shigella spp. May be inhibited.
2. A few nonpathogenic organisms may grow on Salmonella Shigella Agar. These organisms can be differentiated by their ability to ferment lactose and other confirmatory tests.
3. This medium is highly selective and resistant strains of shigellae will not grow on it. It is not recommended for the primary isolation of shigellae(2,6)
4. Media recommended for the isolation of Shigella are Hektoen Enteric and XLD Agars(8)
















Reviews
There are no reviews yet.